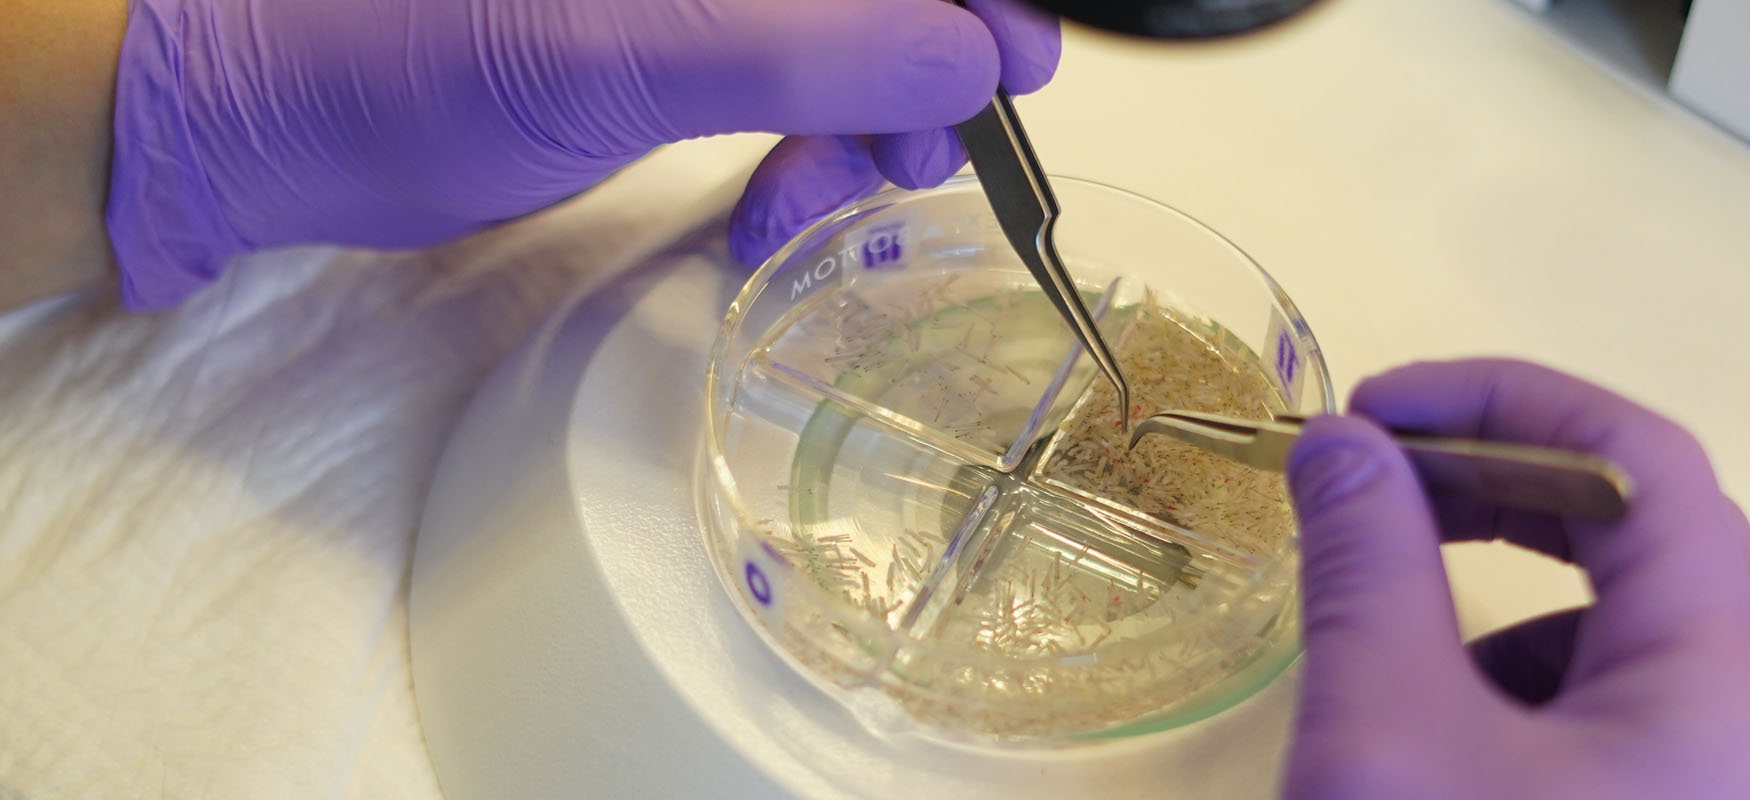

Ilość graftów:
1 200
Po zabiegu:
13 miesięcy
Lekarz:
Dr Piotr Turkowski